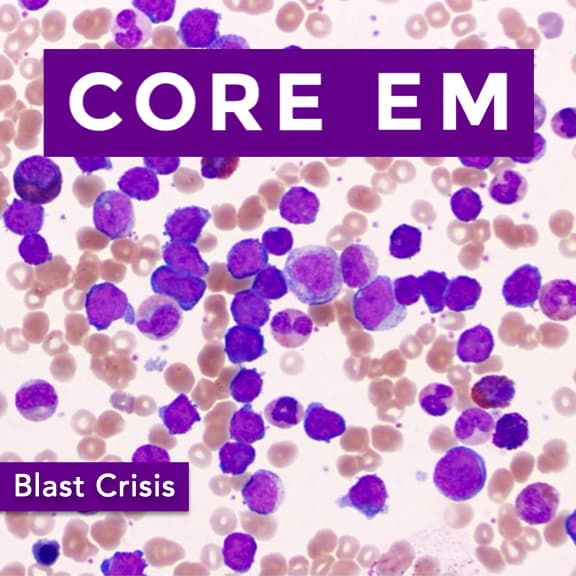
Podcast cover

Thu May 01 2025
We dive into the recognition and management of blast crisis. Hosts: Sadakat Chowdhury, MD Brian Gilberti, MDRead More
Get AI-powered summaries and transcripts for any meeting, phone call, or podcast.
Available on iOS, Android, Mac, and Windows
No transcript available.